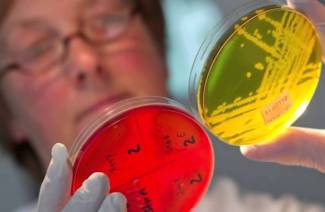

Definir uma doença insidiosa em seu próprio país é difícil. Os primeiros sinais de gripe intestinal não são diferentes de apenas envenenamento ou transtorno ...

Em resposta à desnutrição, o corpo reage muito agudamente: peso constante no estômago, azia, perda de força - estas são as consequências da nutrição ...

O fígado é geralmente chamado de filtro do corpo humano, porque tem a tarefa crucial de limpar o sangue de substâncias tóxicas ....



O corpo humano muitas vezes se torna o "lar" de um grande número de micróbios diversos. Alguns deles praticamente não fazem mal, por ...

Parasitas da ferida? Os remédios populares são um antídoto acessível para um problema delicado. Medicina alternativa oferece métodos para combater vários ...